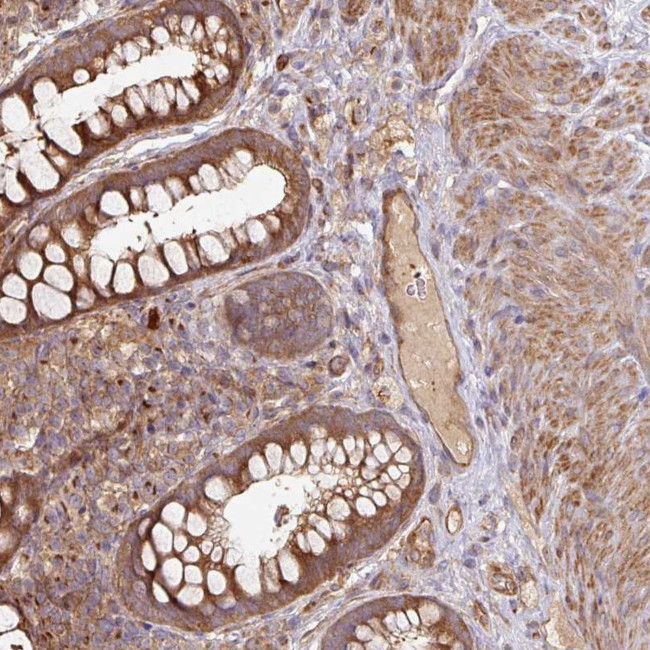
SIK1 Antibody in Immunohistochemistry (Paraffin) (IHC (P))

Search
Invitrogen
SIK1 Polyclonal Antibody
{{$productOrderCtrl.translations['antibody.pdp.commerceCard.promotion.promotions']}}
{{$productOrderCtrl.translations['antibody.pdp.commerceCard.promotion.viewpromo']}}
{{$productOrderCtrl.translations['antibody.pdp.commerceCard.promotion.promocode']}}: {{promo.promoCode}} {{promo.promoTitle}} {{promo.promoDescription}}. {{$productOrderCtrl.translations['antibody.pdp.commerceCard.promotion.learnmore']}}

Please note: We are reviewing Western blot images included in the antibody testing data in our catalog, including those provided by third parties. Unless expressly labeled or annotated as “raw-unedited”, Western blot images included in the antibody testing data in our catalog may have been edited, optimized or otherwise adjusted for presentation.
产品信息
PA5-58296
种属反应
宿主/亚型
分类
类型
抗原
偶联物
形式
浓度
规格
纯化类型
保存液
内含物
保存条件
运输条件
RRID
产品详细信息
Immunogen sequence: YLLLERLKEY RNAQCARPGP ARQPRPRSSD LSGLEVPQEG LSTDPFRPAL LCPQPQTLVQ SVLQAEMDCE LQSSLQWPLF FPVDASCSGV F
Highest antigen sequence identity to the following orthologs: Mouse - 71%, Rat - 71%.
靶标信息
SIK1 may mediate the physiological effects of LKB1, including its tumor suppressor function. SIK1 is also involved in signaling by various proteins like STRAD, NUAK1, NUAK2, BRSK1, BRSK2, QIK, QSK, SIK, MARK1, MARK2, MARK3, MARK4, and MELK that are related to AMPK. Activation of SIK1 by phosphorylation on thr322 can lead to an increase in the catalytic activity of sodium/potassium ATPase alpha subunit at the plasma membrane. This results in an increase in intracellular sodium in intact mammalian cells. The family has been classified in 8 major groups based on sequence comparison of their tyrosine (PTK) or serine/threonine (STK) kinase catalytic domains. The STE group (homologs of yeast Sterile 7, 11, 20 kinases) consists of 50 kinases related to the mitogen-activated protein kinase (MAPK) cascade families (Ste7/MAP2K, Ste11/MAP3K, and Ste20/MAP4K). MAP kinase cascades, consisting of a MAPK and one or more upstream regulatory kinases (MAPKKs) have been best characterized in the yeast pheromone response pathway. Pheromones bind to Ste cell surface receptors and activate yeast MAPK pathway.
仅用于科研。不用于诊断过程。未经明确授权不得转售。
篇参考文献 (0)
生物信息学
蛋白别名: Salt-inducible kinase 1; Serine/threonine-protein kinase SIK1; Serine/threonine-protein kinase SNF1-like kinase 1; Serine/threonine-protein kinase SNF1LK; SIK-1
基因别名: SIK; SIK1; SNF1LK
Entrez Gene ID: (Human) 150094